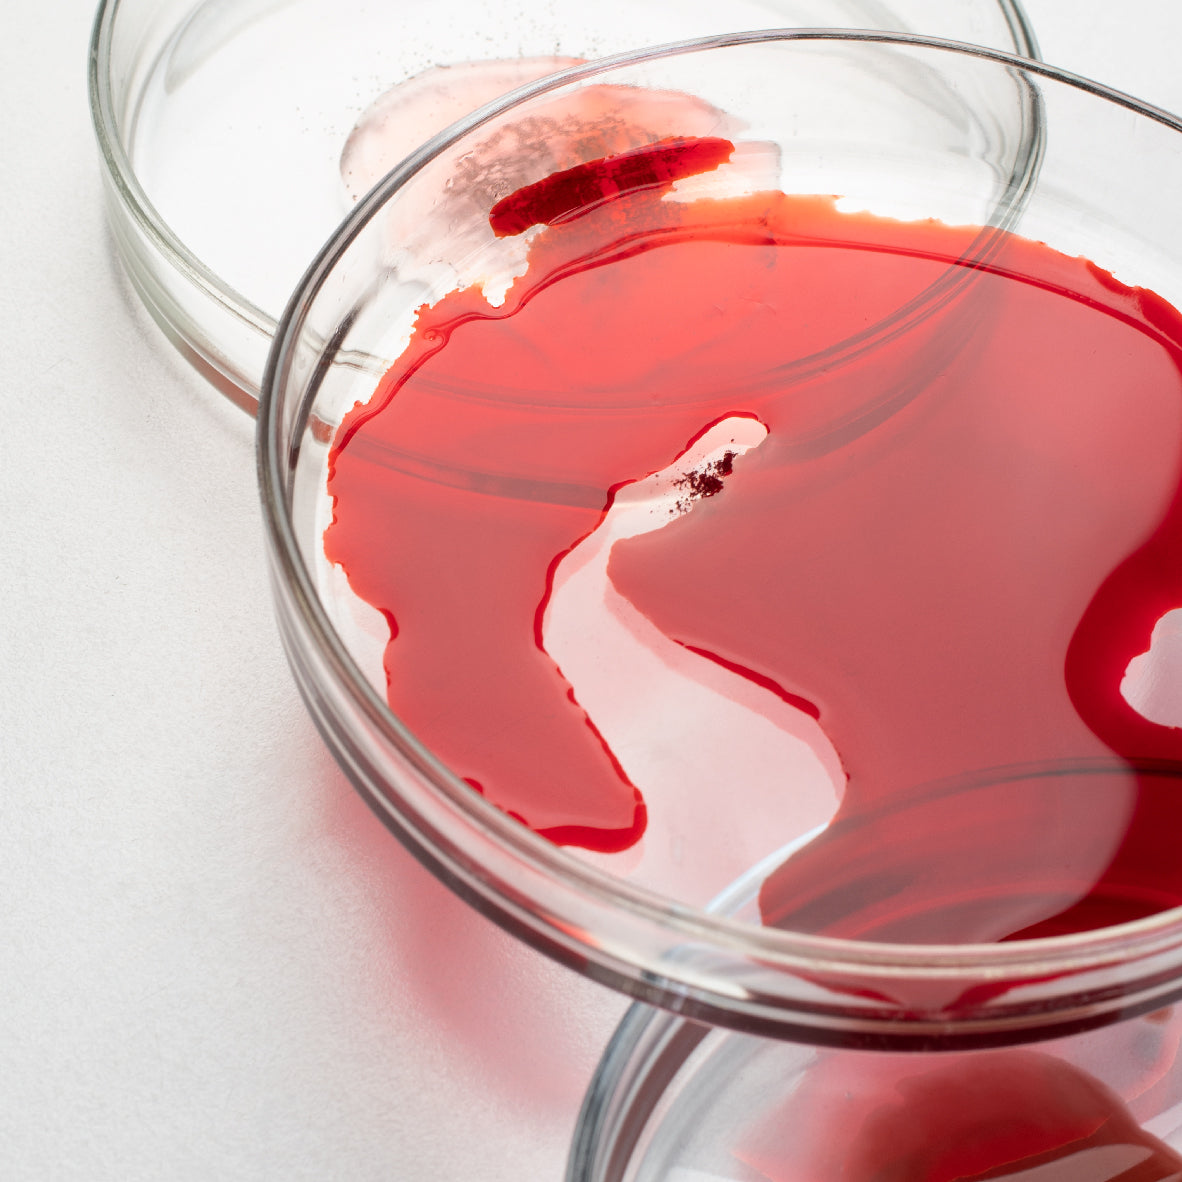

Product High-Quality Ingredients
We don’t think you should settle for questionable ingredients when it comes to your daily nutrition. AG1’s ingredients are sourced from quality partners for absorption, potency, and nutrient density to deliver the Foundational Nutrition your body needs.*

Acerola Cherries
Pinene cherry is a tropical fruit rich in natural vitamin C, containing significantly higher levels of this vitamin than ordinary cherries and citrus fruits. It also contains dietary fiber, potassium, iron, and other nutrients. Its main benefits include helping to boost the immune system, promoting the synthesis of collagen, and providing antioxidant effects, making it an ideal addition to a daily diet for nutritional supplementation.

Sesame extract
Sesamin, the core component in sesame seeds, is a highly effective natural antioxidant. It precisely neutralizes free radicals—the primary culprits behind scalp aging—thereby establishing an antioxidant defense for hair follicles against oxidative damage. This supports hair growth and overall health.

Phospholipids
Phospholipids are a source of healthy fats that play a vital role in the strength and structure of cells throughout the body. The purified lecithin in AG1 is a source of phosphatidylcholine and phosphatidylinositol, two fatty acids that support feelings of balanced mood and vitality.*

Raspberr
Raspberries are fruits rich in vitamin C, dietary fiber, and antioxidants. They help to combat oxidative stress and promote intestinal health. Additionally, they contain trace elements such as manganese and vitamin K, making them highly nutritious.

Honeycomb
Honeycombs possess various therapeutic properties, including antibacterial and anti-inflammatory effects, immune system regulation, promotion of wound healing, antioxidant actions, and improvement of gastrointestinal function. Their main components are natural active substances such as propolis, beeswax, honey, and pollen.

Grape Seed Extract
Grape seed extract provides a source of antioxidants that work to combat oxidative stress. It's rarely consumed in an ordinary diet and the form in AG1 Next Gen is sourced to reach the gut in a more absorbable form than the seeds themselves.*

Pepper Extract
Pepper extract is an active ingredient derived from plants of the pepper family, primarily containing piperine, volatile oils, and polyphenols. It possesses antioxidant, anti-inflammatory properties, and can aid digestion and possess antibacterial effects. It is widely used in the food, health supplement, and pharmaceutical industries.

Biotin
Participates in amino acid and fatty acid metabolism; maintains hair and nail health; supports energy conversion.

Olive oil
Olive extract is a natural compound derived from olive fruits, leaves, or oil. Its main benefits include antioxidant effects, anti-inflammatory properties, protection of cardiovascular health, regulation of blood sugar levels, and antibacterial properties.

Blueberry
Blueberries are rich in nutrients such as anthocyanins, vitamin C, and dietary fiber, and have various health benefits, including antioxidant effects, eye protection, enhanced immunity, and improved digestion. Their natural active ingredients also have a positive impact on cardiovascular health, brain function, and skin condition.

Phaseolus Vulgaris
Phaseolus vulgaris are a highly nutritious type of legume. Their main benefits include helping to regulate blood sugar levels, aiding in weight loss, promoting digestion, and enhancing immunity.

Lipoic Acid
Lipoic acid reduces hunger signals (such as neuropeptide Y) by inhibiting hypothalamic AMPK activity, while simultaneously increasing leptin sensitivity, enhancing satiety, and decreasing food intake.

Ginger
Ginger is an herb that promotes digestive ease and helps support the tolerability of vitamins and minerals in AG1.*

Amla
Amla, also known as “Indian gooseberry,” has a long history in both Ayurvedic and Traditional Chinese Medicine. Modern research has revealed its extensive biological activity, primarily attributed to its rich content of antioxidants such as vitamin C, tannins, phenolic compounds, and flavonoids.

Citrus Bioflavonoids
Bioflavonoids, like hesperidin, are antioxidants found in the skins of oranges and lemons. They support immune defense and combat oxidative stress.*

Magnesium
Magnesium is an essential mineral known to support the nervous system and promote relaxation to help manage stress.

Beetroot
Beet root provides a source of nutrients, like calcium, that are foundational for the body.*

Carrot
The superfood carrots' bright orange color is from its beta-carotene content, an antioxidant and vitamin A precursor.*

Vitamin A
It has the effects of replenishing qi and preventing collapse, strengthening the spleen and benefiting the lungs, as well as promoting the production of body fluids and calming the mind. Modern research has also discovered that it can enhance immunity, regulate the central nervous system, and possess antioxidant properties.

Vitamin E
Antioxidant; Protects cell membrane integrity; Supports cardiovascular health; Promotes skin and blood cell health.

Probiotic
Lactobacillus—rhamnosus GGLactobacillus rhamnosus GG (LGG) is a probiotic supported by hundreds of human studies and has been shown to support the immune system and defend against environmental stress.

Vitamin B
It has the effects of replenishing qi and preventing collapse, strengthening the spleen and benefiting the lungs, as well as promoting the production of body fluids and calming the mind. Modern research has also discovered that it can enhance immunity, regulate the central nervous system, and possess antioxidant properties.

Eleuthero
Eleuthero is an adaptogen that acts alongside rhodiola and ashwagandha to support the body’s response to stress.*

Vitamin C
Antioxidant; Promotes collagen synthesis; Maintains skin/mucous membrane/bone/gum health; Enhances immunity; Facilitates iron absorption; Promotes wound healing.

Folate
Promoting fetal brain and nervous system development; Participating in red blood cell formation; Supporting DNA and protein synthesis.

Pea Sprout Extract
Vitamins C and E, as well as polyphenols found in pea sprout extracts, possess antioxidant properties that help reduce the damage caused by free radicals to the scalp and hair follicles. Amino acids such as lysine and cystine are components of keratin and play a role in repairing damaged hair strands.

Vitamin D
Promotes calcium and phosphorus absorption; maintains bone and dental health; regulates blood calcium balance; supports immune function; prevents rickets.

Ashwagandha
The ashwagandha is a core herbal species in traditional Ayurvedic medicine for regulating physical and mental states, and modern research has also confirmed its positive effects in alleviating stress and improving sleep.
Ferrous Bisglycinateg
Efficient iron supplementation for alleviating symptoms associated with iron deficiency,reduction of gastrointestinal irritation and enhancement of drug tolerance.

Inulin
Inulin is a prebiotic fiber that is known to help support the growth of healthy bacteria in the gut and help support bowel regularity.

Keratin
Homo sapiens hair is a natural fiber primarily composed of keratin and keratin-associated proteins, with keratin accounting for approximately 90%. Its unique molecular structure, Broussonetia papyrifera, and physicochemical properties play a crucial role in hair health and repair.

DHA
DHA can activate the expression of peroxisome proliferator-activated receptor α (PPARα) and carnitine acyltransferase 1C (CPT-1), promoting the oxidative decomposition of fatty acids.

Green Tea Extract
Green camellia sinensis extract - senegalia catechu camellia sinensis compound: By inhibiting senegalia catechu camellia sinensis phenol-O-methyltransferase (COMT) → reduces norepinephrine degradation → prolongs sympathetic nerve signaling → continuously activates β3-AR → promotes the cAMP-PKA pathway → phosphorylates lipid droplets to release fatty acids for energy supply.

Selenium
Antioxidant; Supports immune function; Protects cells from oxidative damage.

Turmeric Extract
The first mechanism by which curcuma longa compounds exert their effects in adipogenesis differentiation is through the regulation of adenosine monophosphate-activated protein kinase (AMPK). Curcuma longa compounds are recognized as AMPK activators.

Zinc
Promotes skin/mucous membrane health; supports immune function; participates in protein and nucleic acid metabolism. Zinc aids in hair follicle recovery and hair growth.

B Complex Vitamins
B1—Thiamin, aka vitamin B1, helps process carbohydrates and protein from the diet to provide the body with energy.
B2—Riboflavin, aka vitamin B2, helps your body convert food into energy and is essential for recycling vitamin B12, a nutrient required to support the nervous system.
B3—Niacin, aka vitamin B3, helps ignite energy production at the cellular level. AG1 has two forms of niacin (nicotinic acid and niacinamide) for enhanced bioavailability and synergy.
B5—Pantothenic acid, aka vitamin B5, is a foundational vitamin known to help break down fatty acids for energy and supports cells that deliver oxygen and nutrients throughout the body.
B6—Pyridoxal-5-phosphate, aka P5P, is the bioactive form of vitamin B6, an important nutrient that supports brain function and the formation of red blood cells.
B12—Methylated B12 is the bioactive form of vitamin B12 that is quickly used by the body to promote healthy red blood cells, energy, and foundational support for the brain. It's especially helpful for those following a vegan or vegetarian diet who may not be getting adequate amounts through dietary sources.

Pomegranate
It contains polyphenolic compounds ,as well as vitamin C and minerals.Its main benefits include antioxidant effects, anti-inflammatory properties, support for cardiovascular health, and improvement of skin condition.






